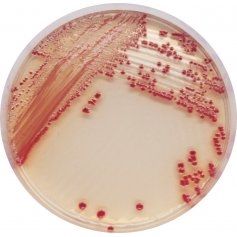
CHROMagar™ Acinetobacter - 5000 ml

LB082
For Group B Streptococcus (GBS) screening
Package size: 5000 ml
DKK 1.125,00
DKK 3.000,00
Not in stock, delivery 1-2 weeks
Chromogenic medium for detecton of Acinetobacter and MDR Acinetobacter spp.
The product is composed of a powder base (B) and 1 supplement (S).
Optional supplement 5000 ml (CR102) for detection of MDR Acinetobacter.
MEDIUM PERFORMANCE:
One unique colour - Red: Detection of A. baumannii from traditional culture media might be a difficult and tedious task due to the abundance of background flora found in collected specimens, especially when using media based on differentiation by the lactose/non-lactose fermentation ability. To overcome these difficulties, CHROMagarTM Acinetobacter was designed as a highly selective medium, allowing the growth of Acinetobacter in conspiciously red colonies, after overnight incubation.
FIRST chromogenic medium for Acinetobacter detection.
Screening of MDR Acinetobacter: This medium can be supplemented to enhance MDR specificity allowing the growth of carbapenem-resistant strains.
TYPICAL APPEARANCE OF MICROORGANISMS
FOR DETEKTION AF ACINETOBACTER Sp:
Acinetobacter sp. → red
Other gram (-) → mostly inhibited or blue
Gram(+) bacteria and yeasts → inhibited
FOR DETEKTION AF MDR ACINETOBACTER (if using the optional supplement CR102):
MDR Acinetobacter → red
Non-MDR Acinetobacter → inhibited
Other gram (-) → mostly inhibited or blue
Gram(+) bacteria and yeasts → inhibited
Acinetobacter baumannii is becoming a major hospital-acquired infecton issue because of its ofen mult-drug resistance (MDR : resistance to C3G, quinolones, carbapenems etc). This contributes to the increase of morbidity and mortality. Actve surveillance is necessary to control its spread in the facilites, to reduce the risk of cross contaminaton, and to identfy the carriers. Rapid identfcaton of patents that are colonized with Acinetobacter would lead to infecton control practces aimed at preventng spread of the organisms.